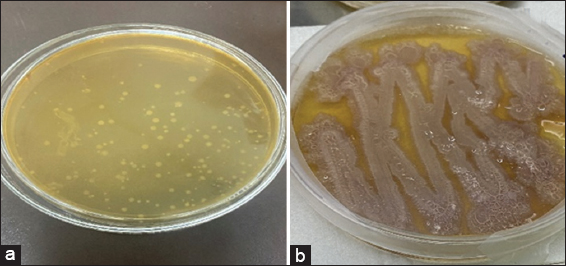

1. INTRODUCTION
Food preservation is the most important issue all over the world, irrespective of whether it is a developed or a developing country. Initially, a ribosomally synthesized peptide having antimicrobial properties from widely known lactic acid bacteria (LAB) has gained attention to be used as a natural food bio-preservative. Those peptides were bacteriocins with bactericidal effects against a broad range of food spoilage and pathogenic bacteria, without causing any harm to human beings. Similarly, some members belonging to Bacillus spp. are also acknowledged for their safe usage in the food and pharma industries. The 2030 goal for sustainable development was set by the United Nations in January 2016. Fulfilling all basic human requirements using the intelligent aspects of sustainable scientific methodology is the most significant sustainable development goal (SDG). It aims to ensure the well-being of all together with an assurance of ending epidemics of AIDS, malaria, tuberculosis, and various other contagious diseases by the year 2030. Looking into this perception, microorganisms play the most important role in maintaining life on this planet. The main principle behind this sustainable food production model involves the reduction of adverse environmental factors on production and to avail the maximum resources efficiently. This allows food industries to adapt technologies and strategies to which helps them in sustaining long-term productivity and affordability.
Research is being done to ensure that sustainable modes can implement the desired outcome and provide new solutions. This made the researchers to allocate the use of LAB of great interest. These microbes play an essential role in sustainable food processing, keeping all environmental and economic aspects. LAB is effectually capable of augmenting food safety, shelf life, thus enhancing nutritional value. LAB plays an essential part in most of food processing industries. Sauerkraut fermentation, malolactic fermentation, winemaking, and Chinese multi-flavored liquor production are some processes where these lactobacilli play significant part in production. Besides, probiotics LAB some Bacillus strains were also given distinct consideration for their capability to activate the immune system of the host, thus holding profound importance in human health-oriented fields like treatment against cancer cells, prevention of intestinal inflammation, and urinary tract infection. They can compete with various food-borne pathogens and thus enable humankind to live a healthier lifestyle. The United Nations SDGs are a blueprint to attain an improved and more sustainable future for all humankind. Some main members of this family are B. subtilis and B. licheniformis, which are commonly known as “generally recognized as safe” [1]. These are gram-positive, aerobic, and endospore-forming bacteria isolated from kefir grains and goat milk. Since more scientific evidence is highlighting the microbial transformation to improve the functionality of food, these fermented foods have gained more value due to their medicinal and nutritional properties [2-4]. Similarly, we all know that the benefits of processed milk in our diet have been well recognized, and the merits of these food products have been known to mankind since the era of ancient civilizations [5,6]. Unlike the other bioprocessed milk products, kefir is a beverage with high probiotic properties that originated in the North Caucasus. On incubating kefir grains in the milk that can be of cow, goat, sheep, or mare, in which both acidic and alcoholic fermentation process takes place together, we get the dairy product with probiotic properties called kefir [7-9].
2. MATERIALS AND METHODS
2.1. Sample Collection and Preparation
Two types of kefir grains, milk, and water kefir, available in the market were collected and stored. 2 g of milk kefir grain is cultured for 2 g of milk kefir grain is cultured for 24 h in 100 mL of sterile skimmed milk at 25°C. The grains were strained from the broth and rinsed with sterile water to remove any kind of clotted milk broth that may remain on the surface of the kefir grains. The fermented broth was removed as milk kefir. Similarly, 2 g of water kefir grains are fermented in 100 mL of water. The broth obtained will then be subjected to isolation and production experiments.
Raw Goat Milk was collected from different local dairies. Serial dilution of the collected samples was done with autoclaved normal saline (0.85%), and then its 10-fold serial dilution was made. Then each dilution was grown aseptically into MRS agar (deMan Rogosa and Sharpe) [10] using the pour plate technique [11].
2.2. Isolation and Screening of Bacteria
0.1 mL of each sample prepared so far was then sub-cultured aseptically into MRS (deMan Rogosa and Sharpe) agar by using the pour plate technique, all plates were then allowed to incubate at 35–37°C for 24–48 h [10]. Plates were checked at different time intervals, and several subculturing was done to get the desired isolates. Colony selection for isolation of desired strain is completely based upon its morphology, including shape of the colony, its size, texture, color of the colony its opacity and elevation. Generally, LAB colonies have general characteristics, namely circular, white to yellowish in color, entire margin, convex elevation, and smooth surface. Once the desired colony with the above criteria was observed on the plates after serial dilution of sources, they were studied under microscopic observations followed by biochemical characterizations, including Gram staining, motility test, endospore test, MR-VP Test, Indole Test, Citrate utilizing test, oxidase, and catalase test.
The bacteriocin-producing bacterial isolates cultured on agar plates were recognized as per the Bergey’s Manual of Systematic Bacteriology. Various other biochemical tests, including Starch Hydrolysis, Casein Hydrolysis, Carbohydrate Fermentation Glucose, Lactose, Sucrose, Mannitol |& Sorbitol were performed for screening the desired isolated colony [12].
2.3. Production and Purification of Bacteriocin
The selected isolated strains were allowed to grow in M17 broth by incubating at 37°C under aerobic conditions for 24–48 h. Broth obtained after fermentation contains the bacteriocin, hence centrifugation of the culture was done at 10,000 rpm for 10 min at 4°C. The cell-free supernatant obtained was filtered through 0.5-micron filter, and then the pH was adjusted to pH 6 by 1N NaOH. Filtered and purified cell-free supernatant (CFS) obtained was kept in a sterile tube till further studies.
2.4 Screening of Bacteriocin-Producing Potent Strains Among all the Isolates Against Indicator Strains
Antibacterial activity of selected strains was tested by using Listeria monocytogenes MTCC 657 and Lactococcus lactis subsp. cremoris procured from IMT Chandigarh as an indicator microorganism by the well diffusion method. Filtered and partially purified CFS of selected isolates grown in M17 medium under optimized conditions for bacteriocin production were used for the well diffusion assay in triplicate. A 50–100 μL neutralized sample of bacteriocin was poured in triplicate wells prepared on BHI soft agar plates with 5 mm diameter triplicate. These wells were then seeded with indicator strains of L. monocytogenes culture. The sample of bacteriocin was kept at 20°C for 4–6 h to diffuse through the agar medium. Plates were then kept for incubation under aerobic conditions at 37°C. Overnight incubation can give the desired zone of inhibition on the plates having a Listeria cell lawn.
2.5. Broad-Spectrum Antibacterial Activity of Bacteriocin
The best bacteriocin producer was selected based on antibacterial effects against L. monocytogenes and L. lactis subsp. cremoris were tested for their broad-spectrum effects using the following strains as indicator ones procured from IMT Chandigarh.
1.Bacillus subtilis
2.Enterococcus faecalis
3.Escherichia coli
4.Staphylococcus aureus
5.Streptococcus mutans
For this test, Agar plates in triplicate were prepared as per the standard composition given by HIMEDIA for the respective strains used as the indicator bacteria. Autoclaved 20 mL media required for the growth of the indicator strain was allowed to solidify in laminar air under aseptic conditions. Glass Petri plates used in pour plating should be sterilized and well labelled for the indicator strains. Once the plates get solidified, the 100 μL liquid broth containing the bacterial culture was poured on the agar media and spread uniformly by using a sterile glass spreader. Once it gets solidified, wells of the same dimensions were made on it by using sterile tips.
The samples containing cell-free supernatant were injected into wells with sterile tips and then they were left to diffuse in the agar media. The seeded plates were sealed with paraffin and allowed to incubate for 24 h and 48 h at 37°C under aerobic conditions. The first well was for positive control that was having NISIN, the second well was loaded with media as negative control, and the third well was loaded with sample isolates showing prominent antibacterial activity against strains used as indicators. Appearance of a clear zone of inhibition was observed after 24 h.
Similarly, tests were done with Methicillin-resistant S. aureus and Vancomycin-resistant Enterococci strains. They were grown overnight under favourable physical conditions and required growth medium, then subculture into fresh broth to attain the desired growth to an OD600 of 0.5. Further dilution was made so that we get 105 cfu/mL as the final concentration, and they were poured into microtiter plates aseptically in triplicate. To 90 μL of bacterial suspension poured in to 96 well-microtiter plate, 2-fold diluted 10 μL of purified bacteriocin will be added and then incubated for 24 h at 37°C. The absorbance was measured at 600 nm to determine the bacterial growth inhibition by bacteriocin in terms of MIC and MBC using a microplate reader. The MIC value is defined as the minimum concentration of bacteriocin that can cause complete inhibition of the indicator strain so that zero growth is observed, whereas the MBC is the lowest concentration of bacteriocin required to kill the bacteria [12].
2.6. Media Optimization for Enhancing the Activity and Study of Various Parameters Affecting Bacteriocin Production
The CFS was prepared as mentioned earlier, and media optimization was done by testing the effects of temp, pH, and duration of fermentation. Along with this, the effects of enzymes on the antibacterial activity of bacteriocins were also studied.
The effect of initial pH was studied on the antimicrobial activity of microbial peptides produced from an isolated strain. A wide range of initial pH 2-12 of liquid M17 broth was adjusted using HCl and NaOH, respectively, in triplicate [13] After incubation, the antibacterial activity was checked and compared with that of the initial one, having a pH value of 7. The indicator strain used here is L. monocytogenes, and the effect of pH was measured by agar diffusion method only.
Similarly, temperature variations were made to observe its effects on antibacterial activity of bacteriocins. For studying thermal effects, a wide range of temperature was made for incubation of CFS obtained from M17 broth for different time intervals. Effects were studied on L. monocytogenes as the test microorganism by measuring its OD at 600 nm and zone of inhibition by agar diffusion assay in triplicates [14].
For the evaluation of enzymes effect on the antibacterial activity of bacteriocins, the enzyme solution (20 μL) was allowed to incubate with 200 μL of CFS containing partially purified bacteriocin. After incubating at 37°C for about 2 h., the temperature was raised to 80°C for 5 min. This causes the enzyme activity to stop, and the effect of bacteriocin treated with enzymes was calculated by measuring the zone of inhibition compared to untreated bacteriocin as a negative control [14-16].
2.7. Phylogenetic Analysis of Isolated Strain
2.7.1. Strain identification
Among all isolates some of the selected strains having broad spectrum antibacterial activity was allowed to go for 16s ribosomal sequencing for strain identification. This identification can help us to relate the emergence of bactericidal activity of the strain and the efficacy of the bacteriocin obtained from that isolate can be further studied.
Based on maximum production of bacteriocin and high antimicrobial activity, isolates obtained from Milk kefir and goat milk were carefully chosen for whole-genome sequencing. Genome sequencing and further molecular studies were done at Cytogene Pvt. Ltd., Lucknow, India. A phylogenetic tree showing the genetic similarities with neighbouring strains was constructed by using the Neighbor-joining process by collecting the sequences from the NCBI database [17].
2.8. Molecular Weight Determination of Bacteriocin using SDS-Polyacrylamide Gel Electrophoresis (PAGE)
MRS broth that was prepared and sterilized in Erlenmeyer conical flasks with a size of 250 ml. Each flask was filled with 100 mL of medium. The flasks were then incubated for a duration of 48 h. at a temperature of 37°C. Subsequently, the culture broth was centrifuged at 8000 rpm for 10 min, the supernatant was collected, and the pelleted cells were discarded. The supernatant collected was further used for Precipitation, dialysis, purification on the column, and subsequently all the fractions were used for SDS-PAGE. The desired saturation range of ammonium sulfate was 40–80%; therefore, precipitation was conducted in three ranges of 0–20%, 20–40%, and then 40–80%.
Molecular weight markers ranging from 0 to 250 kDa were used in the study. Next to the electrophoresis, Coomassie Brilliant Blue was used to stain the gel. The apparent molecular weights of the selected isolate samples were determined by comparison with the mobility of the selected DNA standard markers.
2.9. Statistical analysis
All the above experiments were performed in three replicates, and the mean and standard deviation data were expressed. Microsoft Office data analysis tool pack was used to carry out one-way analysis of variance.
3. RESULT
3.1. Isolation, Identification, and Screening of Bacterial Strain
In this study, the sources of isolation were kefir grains, goat, and cow milk. From the sources collected, about 24 strains were isolated, and among them, only 9 strains were characterized, and biochemical studies were performed.
Both the kefir grains after undergoing the process of revival are visible like as shown in Figure 1a and b and broth collected was used for the isolation process. From the fermented broth the nine isolates showing prominent growth of bacilli and rods on MRS agar plates with different growth patterns colors and morphology were selected up casually. Further studies were made based on their morphological and biochemical characters [Table 1].
 | Figure 1: Images representing (a) Water kefir (b) Milk kefir. [Click here to view] |
Table 1: Biochemical characterization of 9 bacterial strains isolated from kefir grains, cow milk and goat milk.
| Sample code | Isolate code | Gram stain | Indole production | Catalase test | Endospore test | Motility test | Glucose fermentation |
|---|---|---|---|---|---|---|---|
| MK | MKIII | (+) | (-) | (-) | (-) | (-) | (-) |
| MKVI | (+) | (+) | (+) | (-) | (-) | (+) | |
| MKVIII | (+) | (-) | (-) | (-) | (-) | (-) | |
| WK | WKII | (+) | (-) | (-) | (+) | (-) | (+) |
| WKIV | (+) | (-) | (-) | (-) | (-) | (-) | |
| CM | CM1 | (+) | (-) | (-) | (-) | (-) | (-) |
| CM2 | (+) | (-) | (-) | (-) | (-) | (-) | |
| GM | GM1 | (+) | (+) | (+) | (+) | (-) | (-) |
| CW | CW2 | (+) | (-) | (-) | (-) | (-) | (-) |
MK: milk kefir, WK: water kefir, CM: cow milk, GM: goat milk, and CW: cheese whey
The selected isolates were colorless, smooth, and irregular in shape, and the morphological cytology revealed small rod-shaped cells [Figure 2]. All the isolated strains were found to be gram-positive and were showed maximum growth at a temperature of 30°C, optimal at 50°C, but not able to show much growth at 15°C. More characterization was supported by several biochemical tests and carbohydrate fermentation tests using the current taxonomic status according to Bergey’s manual of determinative classification system.
| Figure 2: Colony of selected bacterial isolates on MRS plates (a) and (b). [Click here to view] |
Among the isolated strains of LAB, some strains have shown inhibitory activity towards the L. monocytogenes MTCC657. Further antibacterial tests were performed by using E. faecalis and E. coli as indicator microorganisms [Figure 3].
 | Figure 3: Well diffusion assay on Agar plate (a) Enterococcus faecalis (b) Escherichia coli (c) Bacillus subtilis (d) Streptococcus mutans (e). One way analysis of variance (Tukey HSD Post hoc) was used to calculate the statistical differences among the study groups (P < 0.001 considered to be significant at 95% confidence interval). [Click here to view] |
Visible zone of inhibition can be seen on the plates seeded with GM I, CM I, CM II, MK VI, and FGK IV. Whereas there were some strains which did not show any inhibitory action against L. monocytogenes in agar well diffusion assays study.
Among the isolated strains, 9 strains have shown the remarkable inhibitory activity [Table 1]. Strains showing prominent zone of inhibition were GM and MKVI. These two were tested against other pathogenic bacteria including B. subtilis E. Coli, S. aureus, and S. mutans. Results obtained are depicted in observation chart below [Tables 2-4].
Table 2: Antibacterial activity against Bacillus subtilis.
| S. no. | Sample | Bacteria | Code | Concentration | Zone of Inhibition (mm) (Mean±SD) | P-value$ |
|---|---|---|---|---|---|---|
| 1 | Bacterial culture (Slant) | Bacillus subtilis | GM | 1 mg/mL | 19.9±2.13 | 0.0002* |
| MKVI | 1 mg/mL | 15.3±1.1 | 0.0000# | |||
| 2 | Pos control (NISIN) | +(ve) C | - | 10000 ppm | 10±0.84 | 0.0000@ |
| 3 | Neg. control | −(ve) C | - | - | 0.00 | - |
$ One way analysis of variance (Tukey HSD Post hoc) was used to calculate the statistical differences among the study groups.
* GM compared with MKVI;
# GM compared with positive control;
@ MKVI compared with positive control
Table 3: Antibacterial activity against Streptococcus mutans.
| S. no. | Sample | Bacteria | Code | Concentration | Zone of Inhibition (mm) (Mean±SD) | P-value$ |
|---|---|---|---|---|---|---|
| 1 | Bacterial culture (Slant) | Streptococcus mutans | GM | 1 mg/mL | 0.00 | - |
| MKVI | 1 mg/mL | 9.8±0.42 | 0.5277* | |||
| 2 | Pos control (NISIN) | +(ve) C | - | 1000 ppm | 10±0.62 | |
| 3 | Neg. control | −(ve) C | - | - | 0.00 | - |
$ One way analysis of variance (Tukey HSD Post hoc) was used to calculate the statistical differences among the study groups.
* MKVI compared with positive control
Table 4: Antibacterial activity against Enterococcus faecalis.
| S. no. | Sample | Bacteria | Code | Concentration | Zone of Inhibition (mm) (Mean±SD) | P-value$ |
|---|---|---|---|---|---|---|
| 1 | Bacterial culture (slant) | Enterococcus faecalis | GM | 1 mg/mL | 15.2±1.14 | 0.0013* |
| MKVI | 1 mg/mL | 12.1±1.6 | 0.0168# | |||
| 2 | Pos control (NISIN) | +(ve) C | - | 1000 ppm | 13±0.71 | 0.4207@ |
| 3 | Neg. control | − (ve) C | - | - | 0.00 | - |
$ One way analysis of variance (Tukey HSD Post hoc) was used to calculate the statistical differences among the study groups.
* GM compared with MKVI;
# GM compared with positive control;
@ MKVI compared with positive control
Media optimization studies showed that bacteriocin production and its antibacterial activity are affected by several factors, including media composition, temperature, and time of incubation, initial pH, aeration, and growth rate, etc. There was no activity seen at pH less than 4, whereas remarkable increase was observed with 5–7 [Figure 4]. Maximum activity showing zone of inhibition~21 mm was noticed at pH 7.
 | Figure 4: pH stability effect on antibacterial activity of strain MKVI by using L. monocytogenes as an indicator strain. (pH ranges were compared within group with one-way analysis of variance; P <0.0001 was significant at 95% confidence interval). [Click here to view] |
Similarly, growth of isolated bacteriocin-producing strains in media at a temperature of 37 °C with glucose as a carbon source at a constant pH value of 6.8 was much higher with an OD of 1.5 at 36 h of incubation [Figures 5 and 6].
 | Figure 5: Growth kinetics versus bacteriocin production under optimized culture conditions using strain MKVI. Time points were compared within group with one-way analysis of variance; P <0.0001 was significant at 95% confidence interval). [Click here to view] |
 | Figure 6: Variation in BLIS activity produced by MKVI by changing temperature and pH (BLIS were compared within group with one-way analysis of variance; P <0.0001 was significant at 95% confidence interval). The values were compared between 30°C and 37°C. [Click here to view] |
3.2. Molecular Weight Determination using SDS-PAGE
In this study, the highest precipitation was observed to be at 70% of ammonium sulphate saturation, and then, it is subjected to further purification, though in most cases, recovery of the bacteriocin is found in the range of 60–80% ammonium sulfate saturation. Strains showing prominent antibacterial effects were allowed to run on a Gel having a band containing the proteins that lie in the molecular weight range from 10 to 250 kDa. Lane 1 representing MKVI showed the visible band at 16kDa, whereas no clear band was visible with strain GM [Figure 7].
 | Figure 7: (a) Lane L: Ladder; Lane 1: Purified sample of bacteriocin (MKVI) and Lane 3: Purified sample of bacteriocin (GM). Lane L: Ladder; Lane 1- Purified sample of bacteriocin (MKVI) and Lane 3: Purified sample of bacteriocin (GM). (b) Histogram analysis was made using Image J software. [Click here to view] |
3.3. Identification of Bacterial Isolates with PCR Amplification of 16S Ribosomal DNA
Genomic DNA was isolated from the strain MKVI and GM and by using high–fidelity PCR amplification, the sequence data obtained were aligned and assessed to recognize the isolated bacteria and their closest neighboring strains. Amplification of the 16S rRNA gene sequence was done with the help of universal primers [Table 5]. 104 and 134 ng of Extracted DNA (GM and MKV1) were used for amplification, PCR amplification generated a 1500bp fragment [Figure 8].
Table 5: DNA quantification data.
| S. no. | Sample ID | DNA (ng/µL) |
|---|---|---|
| 1 | GM | 104 |
| 2 | MKV1 | 134 |
 | Figure 8: Gel electrophoresis of 16SrRNA gene showing base pair of isolate GM (1), isolate MKVI (2), DNA size marker (l). [Click here to view] |
Aligned sequence data of sample GM (1318 bp) showed that the Microbe was identified as B. subtilis as it showed the highest similarity of 98.12% with B. subtilis strain LSRBMoFPIKRGCFTRI2 16S ribosomal RNA with accession no. MN882708.1 [Figure 9a].
 | Figure 9: Neighbour-joining tree based on 16S rRNA gene sequences, showing relationships of strain GM (a) and strain MKVI (b) along with their close neighboring member belonging genus Bacillus. [Click here to view] |
Similarly, sample MKV1 (1470 bp) was identified as Bacillus licheniformis as it showed the highest similarity of 96.72% with B. licheniformis strain TT77 16S ribosomal RNA gene with accession no. GQ340470.1 [Figure 9b].
4. DISCUSSION
The presence of antibacterial peptides, i.e., bacteriocins, in fermented dairy and nondairy products is known to everyone [18]. In this study, fermented kefir drink is the major source of bacteriocin production. Around 25 different kinds of bacterial isolates were found in this study, which were isolated from milk kefir, water kefir, cow milk, and goat milk. Here, we have tried to screen several bacteria that were able to show antibacterial activity against some common food-borne pathogens. Among all isolates, 9 have shown desirable anti-bacterial activity, but only two strains, MKVI and GM, could show broad-spectrum antimicrobial properties [19,20]. Phylogenetic trees showed that both the selected isolates belong to the Bacilli family, which possessed strong inhibitory action toward both Gram-positive and Gram-negative bacteria [21]. Effects of various physical parameters are mentioned, which show the conditional stability in the antimicrobial activity of isolates. Bacteriocin production was seemed to be maximized at optimum conditions, i.e., at pH 7 and temperature 37°C, whereas its activity was reported to be variable. Tolerance level of enzymes was also studied, which has shown a remarkable effect on their activity [22,23].
5. CONCLUSION
Here in this study, we have reported a partially purified bacteriocin having a molecular weight of approximately 16kDa that showed prominent antibacterial activity against a wide range of both Gram-positive and Gram-negative bacterial populations. This bacteriocin was produced from the B. licheniformis isolated from milk kefir. The study has tried to show that probiotic drinks like kefir not only deal with gut health or abdominal microbiota in humans, but they can also be proven to be active against various pathogenic microbes, which can cause serious illness to humankind.
6. ACKNOWLEDGMENT
Authors are thankful to Lovely Professional University and GSVM Medical college for providing the laboratory facilities required to carry out Research work.
7. AUTHOR CONTRIBUTIONS
All authors made significant contributions to conception and design, acquisition of data, or its analysis and interpretation. All took part in drafting the article or revising it critically for important intellectual content, agreed to submit to the current journal, gave final approval of the version to be published and agreed to be accountable for all aspects of the work. All the authors are eligible to be an author as per the International Committee of Medical Journal Editors (ICMJE) requirements/guidelines.
8. FUNDING
Author hereby declares that this research received no specific grant from any funding agencies.
9. CONFLICTS OF INTEREST
The authors report no financial or any other kind of conflicts of interest during this work.
10. ETHICAL APPROVALS
This study does not comprise any kind of experiments on animals or human subjects.
11. DATA AVAILABILITY
The data supporting this study’s findings are available on request from the corresponding author.
12. USE OF ARTIFICIAL INTELLIGENCE (AI)-ASSISTED TECHNOLOGY
The authors confirm that there was no use of AI-assisted technology for assisting in the writing or editing of the manuscript and no images were manipulated using AI.
13. PUBLISHER’S NOTE
All claims expressed in this article are solely those of the authors and do not necessarily represent those of the publisher, the editors, and the reviewers. This journal remains neutral about jurisdictional claims in published institutional affiliation.
REFERENCES
1. Sharma G, Dang S, Gupta S, Gabrani R. Antibacterial activity, cytotoxicity, and the mechanism of action of bacteriocin from Bacillus subtilis GAS 101. Med Princ Pract 2018;27:186-92. [CrossRef]
2. Champagne CP, da Cruz AG, Daga M. Strategies to improve the functionality of probiotics in supplements and foods. Curr Opin Food Sci 2018;22:160-6. [CrossRef]
3. Turkmen N. The Nutritional Value and Health Benefits of Goat Milk Components. Nutrients in Dairy and Their Implications on Health and Disease. United States:Academic Press;2017. 441-9. [CrossRef]
4. Browne K, Chakraborty S, Chen R. A new era of antibiotics:The clinical potential of antimicrobial peptides. Int J Mol Sci2020;21:7047. [CrossRef]
5. Abd El-Salam MH. Fermented milks-middle eastern fermented milks. In:Fuquay JW, editor. Encyclopedia of Dairy Sciences. 2nd ed. San Diego, CA, USA:Academic Press;2011. 503-6. [CrossRef]
6. Rosa DD, Dias MM, Grzeskowiak LM, Reis SA, Conceiçao LL, Peluzio MD. Milk kefir:Nutritional, microbiological and health benefits. Nutr Res Rev. 2017;30:82-96. [CrossRef]
7. Moretti AF, Moure MC. Water kefir, a fermented beverage containing probiotic microorganisms:From ancient and artisanal manufacture to industrialized and regulated commercialization. Future Foods 2022;5:100123. [CrossRef]
8. Garofalo C, Ferrocino I, Reale A, Sabbatini R, Milanovic V, Alkic-Subašic M, et al. Study of kefir drinks produced by backslopping method using kefir grains from Bosnia and Herzegovina:Microbial dynamics and volatilome profile. Food Res Int 2020;137:109369. [CrossRef]
9. Ganatsios V, Nigam P, Plessas S, Terpou A. Kefir as a functional beverage gaining momentum towards its health promoting attributes:A review. Beverages 2021;7:48. [CrossRef]
10. Guessas B, Kihal M. Characterization of lactic acid bacteria isolated from Algerian arid zone raw goats'milk. Afr J Biotechnol 2004;3:339-42. [CrossRef]
11. Thakur M, Deshpande HW, Bhate MA. Isolation and identification of lactic acid bacteria and their exploration in non-dairy probiotic drink. Int J Curr Microbiol Appl Sci 2017;6:1023-30. [CrossRef]
12. Ali AA. Isolation and identification of Lactic Acid Bacteria isolated from traditional drinking yoghurt in Khartoum state, Sudan. Curr Res Bacteriol 2011;4:16-22. [CrossRef]
13. Afrin S, Hoque MA, Sarker AK, Satter MA, Bhuiyan MN. Characterization and profiling of bacteriocin-like substances produced by lactic acid bacteria from cheese samples. Access Microbiol 2021;8:3:000234. [CrossRef]
14. Sonsa-Ard N, Rodtong S, Chikindas ML, Yongsawatdigul J. Characterization of bacteriocin produced by Enterococcus faecium CN-25 isolated from traditionally Thai fermented fish roe. Food Control 2015;54:308-16. [CrossRef]
15. Ahmed Z, Wang Y, Ahmad A. Kefir and health:A contemporary perspective. Crit Rev Food Sci Nutr 2013;53:422-34. [CrossRef]
16. Shokri D, Zaghian S, Khodabakhsh F, Fazeli H, Mobasherizadeh S, Ataei B. Antimicrobial activity of a UV-stable bacteriocin-like inhibitory substance (BLIS) produced by Enterococcus faecium strain DSH20 against vancomycin-resistant Enterococcus (VRE) strains. J Microbiol Immunol Infect 2014;47:371-6. [CrossRef]
17. Epparti P, Eligar SM, Sattur AP, Kumar G, Halami PM. Characterization of dual bacteriocins producing Bacillus subtilis SC3.7 isolated from fermented food. Food Sci Technol 2022;154:112854. [CrossRef]
18. Zangeneh M, Khorrami S, Khalegi M. Bacteriostatic activity and partial characterization of the bacteriocin produced by L. plantarum sp. isolated from traditional sourdough. Food Sci Nutr 2020;8:6023-30. [CrossRef]
19. Chen X. Structural and functional characterization of three polyketide synthase gene clusters in Bacillus amyloliquefaciens FZB42. J. Bacteriol2006;188:4024-36. [CrossRef]
20. Javed I, Ali MI, Ahmed B, Humro BI, Hameed A, Ahmed S. Optimization and partial purification of bacteriocins from Enterococcus spp. indigenous to Pakistan. Food Biotechnol 2011;25:130-9. [CrossRef]
21. Hanafy AM, Al-Mutairi AA, Al-Reedy RM, Al-Garni SM. Phylogenetic affiliations of Bacillus amyloliquefaciens isolates produced by a bacteriocin-like substance in goat milk. J Taibah Univ Sci 2016;10:631-41. [CrossRef]
22. Aran HK, Biscola V, El-Ghaish S, Jaffrès E, Dousset X, Pillot G, et al. Bacteriocin-producing Enterococcus faecalis KT2W2G isolated from mangrove forests in southern Thailand:Purification, characterization, and safety evaluation. Food Control 2015;54:126-34. [CrossRef]
23. Ahmadova A, Todorov SD, Choiset Y, Rabesona H, Zadi TM, Kuliyev A, et al. Evaluation of antimicrobial activity probiotic properties, and safety of wild strain Enterococcus faecium AQ71 isolated from Azerbaijani Motal cheese. Food Control 2013;30:631-41. [CrossRef]